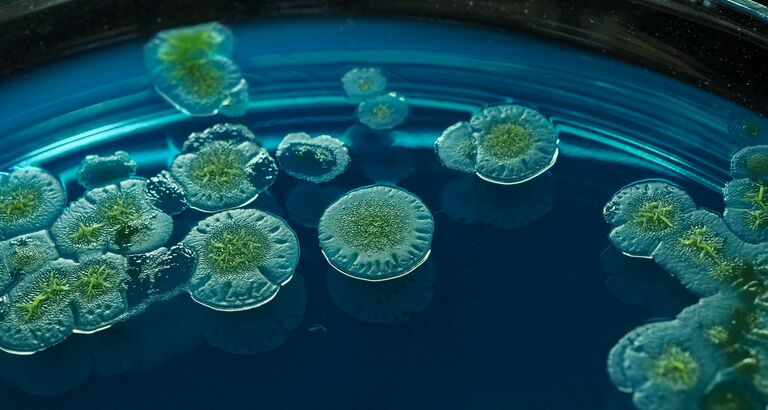

Brødkrumme
Mikrober skal skabe bæredygtige proteiner til fremtidens fødevarer
Mikrosvampe skal omdanne biologisk affald til værdifulde fødevareingredienser. Det er målet i et nyt forskningsprojekt, der vil bidrage til reduktion af klimaudledninger fra animalsk fødevareproduktion og til at sikre mad til verdens voksende befolkning.
Ved at erstatte animalske fødevareproteiner fra for eksempel oksekød og mælk med proteiner produceret af mikrober, kan klimapåvirkningen fra den globale fødevareproduktion reduceres med 70-90 procent. Derved mindskes også behovet for arealer til at producere dyrefoder, som i dag udgør 80 procent af Danmarks samlede landbrugsareal.
Det er et af potentialerne ved det nye forskningsprojekt, UPCYFUN, som Innovationsfonden investerer knap 22 millioner kroner i, og som ledes af virksomheden ProteinFrontiers og involverer universiteter, GTS, landbruget, bioteknik-industrien og teknologivirksomheder.
Projektet adresserer både Trepartsaftalens mål om at producere danske fødevarer på mindre landbrugsjord med et mindre klima- og miljøaftryk og den globale udfordring med at sikre tilstrækkeligt protein til verdens befolkning, der vokser til 10 milliarder i 2050 og vil kræve 30-60 procent stigning i den globale fødevareproduktion.
- Det handler både om global fødevaresikkerhed og om at sikre Danmarks styrkeposition som eksportør af fødevarer. Danmark er bagud i denne udvikling og derfor er det glædeligt, at vi nu får startet udviklingen, så teknologien og kapaciteten er klar, når mikrobebaseret fødevareproduktion rammer massemarkedet indenfor 5-10 år, siger Projektets leder Niels Kristian Sørensen fra ProteinFrontiers.
Vil give Danmark førerrolle i globalt kapløb
UPCYFUN-projektet er centreret om oparbejdning af biostrømme til produktionsmedier, dvs mad til mikroberne, og udvikling af mikrobielle svampestammer, der effektivt kan udnytte disse medier. Ved at udnytte teknologi og viden fra Danmarks styrkeposition indenfor biotek og farma vil UPCYFUN skabe en ny fermenteringsindustri for fødevarer baseret på bæredygtige produktionsmedier. Det kræver nye samarbejder på tværs af eksisterende sektorer og skabelsen af en helt ny fødevare-værdikæde. Et samarbejde, som partnerskabet i projektet har muliggjort.
- Proteinproduktion ved fermentering betyder på ingen måde at landbruget skal nedlægges. Tværtimod spiller landbruget en nøglerolle som leverandør af råvarer til denne nye industri, og i fremtiden måske også som producenter af fødevareproteiner ved fermentering som sidestykke til andelsmejerierne, der successfuldt transformerede dansk landbrug for over 100 år siden, siger Niels Kristian Sørensen.
- Teknologien er velkendt fra enzym- og farmaindustrien, men den skal udvikles og tilpasses til produktion af proteiner til human ernæring – altså mad. Prisen skal være konkurrencedygtig med traditionelle fødevarer og så lav, at alle har råd til sund og proteinrig kost. Der er et globalt kapløb i gang hvor Danmark har alle muligheder for at blive førende, pointerer han.
UPCYFUN har følgende konkrete projektmål:
- Udvikling af produktionsmedier baseret på bio-strømme fra landbrug, fødevare- og biotekindustrien.
- Screening og optimering af mikrobielle svampestammer til at udnytte komplekse biostrømme og producere mælkeproteiner.
- Udvikling af en platform, der kan bruges til at finde den bedste kombination af biostrømme og mikrobielle svampestammer ved hjælp af dataanalyse bl.a. med brug af kunstig intelligens.
- Etablering af en fødevaregodkendt proteinproduktion baseret på biostrømme via præcisionsfermentering.
Virksomheden ProteinFrontiers har gennem de sidste tre år skabt et fundament for UPCYFUN både gennem teknologisk udvikling og skabelsen af et netværk omkring fermenterings-producerede fødevareproteiner. På den baggrund er det lykkedes at samle et konsortium, der tilsammen danner et unikt team både i forhold til forskning, udvikling og forretningsudviklingen.
Fakta
- Innovationsfondens investering: 21.704.807 mio. kr.
- Samlet budget: 29.522.519 mio. kr.
- Varighed: 4 år
- Officiel titel: UPCYFUN
Partnere i projektet:
Protein Frontiers er en ung virksomhed men ejerne har alle årtiers erfaring indenfor landbrug og fødevarer. De er eksperter indenfor bioteknologi herunder konstruktion af mikrobielle cellefabrikker og fermentering. Derudover har de stor erfaring med innovation og strategisk forretningsudvikling. Kernekompetencen er at oparbejde biostrømme til billige produktionsmedier, matche dem med cellefabrikker og derved skabe effektiv og konkurrencedygtig produktion af fødevareproteiner.
Danmarks Tekniske Universitet, Institut for Bioteknologi og Biomedicin er eksperter i mikrobiel svampegenetik, mikrobielle cellefabrikker, fermentering og automatisering af laboratoriearbejdsgange vha robotter. De har udviklet en avanceret robotstyret platform til screening der kan finde de bedst egnede mikrober til specifikke produktions formål blandt tusindvis af stammer i DTUs store samling af mikrobielle svampestammer.
Aalborg Universitet, Institut for Kemi og Biovidenskab har ekspertise indenfor bioraffinering og mikrobiel svampe-teknologi herunder udvikling af cellefabrikker til at producere specifikke molekyler såsom proteiner. AAU anvender state-of-the-art molekylære analytiske metoder (genomics, transcriptomics, proteomics, metabolomics) og genetiske metoder såsom Crispr, der omsættes til produkter og industrielle processer.
Vestjyllands Andel er Danmarks 3. største andelsgrovvareselskab med en koncernomsætning på 4,6 mia. kr. i seneste regnskabsperiode. Med fokus på praktisk innovation udvikler og leverer Vestjyllands Andel kvalitetsfoderløsninger til konventionel, økologi og non-gm m.v. Samtidig investerer og engagerer grovvareselskabet sig i den grønne omstilling - under behørig hensyntagen til klima, vandmiljø, fossil reduktion og dansk landbrug. Vestjyllands Andel har pr. 31/12-2024 4.094 medlemmer og beskæftiger 292 medarbejdere.
Lyras har udviklet ”raslysation”, en teknologi baseret på UV-lys der skånsomt og effektivt dræber uønskede mikroorganismer i uklare væsker, som en klimavenlig erstatning til traditionelle og mere energikrævende metoder. De producerer raslysation udstyr til en række industrier, herunder fødevare- og biotekindustrien. Sterilisation af medie til fermentering er vigtig for undgå at uønskede mikrober vokser frem og ødelægger fermenteringen.
Teknologisk Institut bygger bro mellem udvikling i laboratoriet og industriel produktion. De har stor ekspertise og faciliteter til at udvikle og opskalere processer indenfor bioraffinering, fermentering og fødevarer i deres nyligt etablerede og stort anlagte ”Biosolutions Technology Center”. Med deres store viden kan de validere processerne for omdannelse af biostrømmene til værdifulde fødevareingredienser og dokumentere bæredygtigheden.
HNH Consult er en enkeltmandsvirksomhed hvor ejeren er en teknisk dygtig opfinder. Efter en karriere på CERN (European Organization for Nuclear Research) i Schweiz har ejeren i flere årtier udviklet og produceret laboratorie- og små-skala produktionsudstyr til industrier indenfor fødevarer, bioteknologi, farma og kemi. HNH Consult vil være med til at etablere sensorer og analyseudstyr der er grundlaget for en data-drevet innovation.
Pexinno er en enkeltmandsvirksomhed hvor ejeren har årtiers erfaring indenfor mikrobiologi, proteinkemi og fermentering i den bioteknologiske industri. Derudover har ejeren i en lang årrække arbejdet med at etablere data science og har udviklet et koncept for ”Det Digitale Laboratorium” hvor data skabt i den fysiske verden opsamles og analyseres bl.a, ved brug af kunstig intelligens. Herved skabes viden og indsigter der er kernen i data-drevet innovation.
